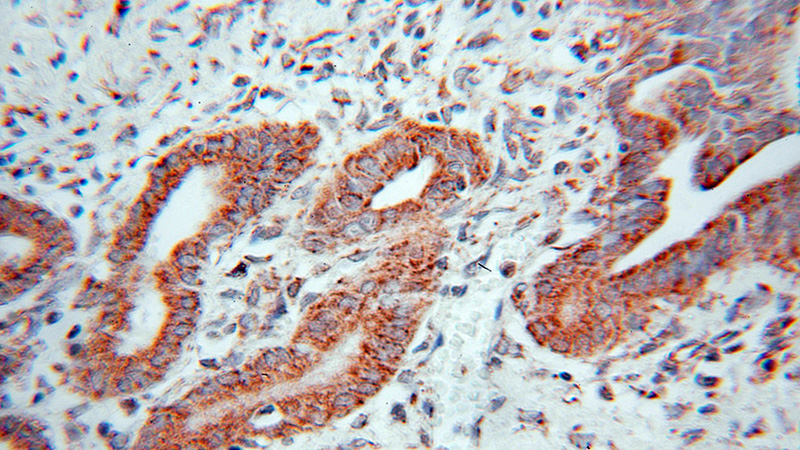
Immunohistochemical of paraffin-embedded human pancreas cancer using Catalog No:114144(PPP1CC antibody) at dilution of 1:100 (under 10x lens)

-
Product Name
PPP1CC antibody
- Documents
-
Description
PPP1CC Rabbit Polyclonal antibody. Positive IP detected in HEK-293 cells. Positive WB detected in MCF7 cells, HEK-293 cells, HEK-293T cells, L02 cells, mouse brain tissue. Positive IHC detected in human pancreas cancer tissue. Observed molecular weight by Western-blot: 35 kDa
-
Tested applications
ELISA, WB, IHC, IP
-
Species reactivity
Human,Mouse,Rat; other species not tested.
-
Alternative names
PP1 Gamma antibody; PP 1G antibody; PPP1CC antibody; PPP1G antibody
-
Isotype
Rabbit IgG
-
Preparation
This antibody was obtained by immunization of PPP1CC recombinant protein (Accession Number: NM_002710). Purification method: Antigen affinity purified.
-
Clonality
Polyclonal
-
Formulation
PBS with 0.1% sodium azide and 50% glycerol pH 7.3.
-
Storage instructions
Store at -20℃. DO NOT ALIQUOT
-
Applications
Recommended Dilution:
WB: 1:200-1:2000
IP: 1:200-1:2000
IHC: 1:20-1:200
-
Validations

MCF7 cells were subjected to SDS PAGE followed by western blot with Catalog No:114144(PPP1CC antibody) at dilution of 1:300
Immunohistochemical of paraffin-embedded human pancreas cancer using Catalog No:114144(PPP1CC antibody) at dilution of 1:100 (under 10x lens)

IP Result of anti-PPP1CC (IP:Catalog No:114144, 4ug; Detection:Catalog No:114144 1:500) with HEK-293 cells lysate 2000ug.
-
Background
PPP1CC, also named as PP-1G, belongs to the PPP phosphatase family and PP-1 subfamily. Protein phosphatase 1 (PP1) is essential for cell division, and participates in the regulation of glycogen metabolism, muscle contractility and protein synthesis. It is involved in regulation of ionic conductances and long-term synaptic plasticity. PPP1CC may play an important role in dephosphorylating substrates such as the postsynaptic density-associated Ca2+/calmodulin dependent protein kinase II.
-
References
- Huang C, Cao W, Liao R. PP1γ functionally augments the alternative splicing of CaMKIIδ through interaction with ASF. American journal of physiology. Cell physiology. 306(2):C167-77. 2014.
- Liao RJ, Tong LJ, Huang C. Rescue of cardiac failing and remodelling by inhibition of protein phosphatase 1γ is associated with suppression of the alternative splicing factor-mediated splicing of Ca2+/calmodulin-dependent protein kinase δ. Clinical and experimental pharmacology & physiology. 41(12):976-85. 2014.
Related Products / Services
Please note: All products are "FOR RESEARCH USE ONLY AND ARE NOT INTENDED FOR DIAGNOSTIC OR THERAPEUTIC USE"
